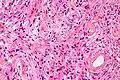
Менинготелиоматозная эпендимома

Менингиома
| Менингиома | |
|---|---|
 Компьютерная томограмма с контрастным усилением, демонстрирующая интенсивно накапливающую контрастный препарат менингиому | |
| МКБ-11 | XH11P5 |
| МКБ-10 | C70, D32 |
| МКБ-10-КМ | D32.9 |
| МКБ-9 | 225.2 |
| МКБ-9-КМ | 239.7[1] |
| МКБ-О | M9530/0 |
| OMIM | 607174 |
| DiseasesDB | 8008 |
| eMedicine | neuro/209 radio/439 |
| MeSH | D008579 |
Менингио́ма (арахноидэндотелио́ма) — опухоль, растущая из клеток паутинной мозговой оболочки, а именно арахноидального эндотелия — ткани, окружающей мозг. Вопреки распространённому убеждению, не является опухолью твёрдой мозговой оболочки. Сам термин и анатомическая классификация, используемые и ныне, введены американским нейрохирургом Кушингом в 1922 году.[2]
Патологическая анатомия

Макроскопически опухоль в большинстве случаев представляет собой хорошо отграниченный узел округлой или подковообразной формы, нередко спаянный с твёрдой мозговой оболочкой. Встречаются и плоские узлы. По величине варьируют от нескольких миллиметров до 15 см и более в диаметре. Консистенция менингиом плотная. В большинстве случаев опухоль окружена плотной капсулой. На разрезе ткань менингиомы серо-жёлтая. Цвет может варьировать. Наличие кист не характерно[3].
Гистологическая классификация
Существует несколько классификаций опухолей центральной нервной системы. Они периодически обновляются, что создаёт определённую терминологическую путаницу[4]. Первая классификация ВОЗ опухолей нервной системы была издана в 1979 году в Женеве[5]. В 1993 году появилось второе издание[6], а в 2000-м и 2007-м — третье и четвёртое, соответственно[4].
| Четвёртое издание гистологической классификации опухолей ВОЗ 2007 года | ||
|---|---|---|
| Код МКБ-О | Степень злокачественности (G=1) | |
Типическая менингиома
|
* 9530/0
|
G = I |
| Атипическая менингиома | 9539/1 | G = II |
| Хордоидная менингиома | 9538/1 | G = II |
| Светлоклеточная менингиома | 9538/1 | G = II |
| Анапластическая менингиома | 9530/3 | G = III |
| Рабдоидная менингиома | 9538/3 | G = III |
| Папиллярная менингиома | 9538/3 | G = III |
Менинготелиоматозная менингиома состоит из мозаикоподобно расположенных клеток с овальным или округлым ядром, которые содержат умеренное количество хроматина. Строма опухоли представлена немногочисленными сосудами и тонкими тяжами соединительной ткани, которые окаймляют клеточные поля. Характерны концентрические структуры из наслаивающихся одна на другую уплощённых опухолевых клеток. Центр новообразования часто обызвествлён[3].
Фиброзная менингиома состоит из фибробластоподобных клеток, которые располагаются параллельно друг другу и складываются в переплетающиеся между собой пучки, содержащие соединительнотканные волокна. Ядра вытянутые. Могут встречаться концентрические структуры и псаммомные тельца[3].
Переходная менингиома включает элементы менинготелиоматозной и фиброзной менингиом[3].
Псаммоматозная менингиома содержит большое количество псаммомных телец[3].
Ангиоматозная менингиома обильно васкуляризирована, содержит большое количество кровеносных сосудов[7].
Микрокистозная менингиома содержит большое количество микрокист, окружённых опухолевыми клетками звёздчатой формы[8].
Секреторная менингиома является редким гистологическим вариантом данного новообразования. Для неё характерна секреция веществ, которые формируют гиалиновые включения[9].
Менингиомы с обилием лимфоцитов по определению содержат большое количество включений лимфоцитарных масс.
Для метапластических менингиом характерна метаплазия (трансформирование) менинготелиальных клеток в клетки другого типа (к примеру, адипоциты)[10].
Менинготелиоматозная эпендимома
Менинготелиоматозная эпендимома Фиброзная менингиома
Фиброзная менингиома_transitional_type.jpg) Переходная менингиома
Переходная менингиома Ангиоматозная менингиома
Ангиоматозная менингиома Секреторная менингиома
Секреторная менингиома Папиллярная менингиома
Папиллярная менингиома Анапластическая менингиома
Анапластическая менингиома Атипическая менингиома
Атипическая менингиома Хордоидная менингиома
Хордоидная менингиома Микрокистозная менингиома
Микрокистозная менингиома
В подавляющем большинстве случаев менингиома — это доброкачественное новообразование, однако возможны и злокачественные варианты. Согласно существующей классификации ВОЗ в зависимости от гистологической картины существует три типа менингиом[11]:
- Grade-1 (1-я степень злокачественности): доброкачественные, медленно растущие образования, без атипии, не инфильтрирующие окружающие ткани. Характеризуются благоприятным прогнозом и низкой частотой рецидивирования. Включает 9 подтипов. Составляет 94,5 % от всех менингиом.
- Grade-2 (2-я степень злокачественности): атипичные, характеризующиеся более агрессивным, быстрым ростом, более высокой частотой рецидивирования и менее благоприятным прогнозом. Включает 3 подтипа. Составляет 4,7 % от всех менингиом.
- Grade-3 (3-я степень злокачественности): злокачественные новообразования с неблагоприятным прогнозом, высокой частотой рецидивирования, агрессивно растущие и вовлекающие окружающие ткани в процесс. Включает 3 подтипа. В среднем 1 % всех менингиом. Чаще встречается у мужчин[11].
Эпидемиология
Составляют 13—25 % от всех первичных внутричерепных новообразований.[12] Средняя распространённость симптоматических менингиом (имеющих клинические проявления) в популяции составляет 2,0/100 000 населения. В то же время распространённость асимптоматических (бессимптомных) менингиом составляет 5,7/100 000 населения[13]. Асимптоматические менингиомы являются находкой 1—2,3 % всех аутопсий[14]
Менингиомы чаще встречаются у женщин. Соотношение мужчины:женщины в группе пациентов с менингиомами составляет от 1:1,4 до 1:2,6[15][16].
Локализация

Наиболее часто внутричерепные менингиомы располагаются парасагиттально и на фальксе (25 %). Конвекситально — в 19 % случаев. На крыльях основной кости — 17 %. Супраселлярно — 9 %. Задняя черепная ямка — 8 %. Ольфакторная ямка — 8 %. Средняя черепная ямка — 4 %. Намет мозжечка — 3 %. В боковых желудочках, большом затылочном отверстии и зрительном нерве — по 2 %.[17] Поскольку паутинная мозговая оболочка покрывает и спинной мозг, то возможно и развитие так называемых спинальных менингиом. Данный вид новообразований является самой частой интрадуральной экстрамедуллярной опухолью спинного мозга у человека[18].
Клинические проявления
Специфической неврологической симптоматики у менингиом нет. Зачастую заболевание может протекать бессимптомно годами, а первым его проявлением в большинстве случаев становится головная боль. Она также не носит специфического характера и чаще всего представляется больному как тупая, ноющая, распирающая, разлитая боль в лобно-височной области с двух сторон в ночные и утренние часы.
Симптомы заболевания зависят от расположения опухоли и могут выражаться следующим образом:
- слабость в конечностях (парез);
- снижение остроты зрения и выпадение полей зрения;
- появление двоения в глазах и опущение века;
- нарушение чувствительности в различных участках тела;
- эпилептические приступы;
- появление психоэмоциональных расстройств;
- просто головные боли.
Запущенные стадии заболевания, когда менингиома, достигая больших размеров, вызывает отёк и сдавление мозговой ткани, что приводит к резкому повышению внутричерепного давления, проявляются обычно сильными головными болями с тошнотой, рвотой, угнетением сознания и реальной угрозой для жизни пациента.
Диагностика
Для диагностики менингиом используются следующие методы нейровизуализации: МРТ, КТ, ПЭТ, селективная и неселективная церебральная ангиография, сцинтиграфия.
МРТ

В настоящее время МРТ с контрастным усилением является ведущим методом диагностики менингиом практически любой локализации. МРТ позволяет визуализировать васкуляризацию опухоли, степень поражения артерий и венозных синусов, а также взаимоотношения между опухолью и окружающими структурами. На нативных T1-взвешенных МРТ большинство менингиом не отличаются по интенсивности от коры головного мозга. Фиброматозные менингиомы могут быть по интенсивности и ниже коры. На T2-взвешенных МРТ менингиомы обычно повышенной интенсивности, отёк также хорошо виден на T2-взвешенных МРТ. Интенсивное контрастное усиление выявляется у 85 % менингиом. У менингиом часто встречается так называемый «дуральный хвост», участок прилежащей ТМО, интенсивно накапливающий КВ. Эта ТМО может быть как опухолево, так и реактивно изменённой. «Дуральный хвост» встречается у 65 % менингиом и только у 15 % других опухолей. Поэтому он хотя и не специфичен для менингиомы, но позволяет более точно высказаться в её пользу. Среди недостатков этого метода необходимо отметить высокую частоту ложноотрицательных результатов в отношении диагностики наличия кальцинатов и очагов кровоизлияний.
КТ
КТ с контрастированием сопровождается умеренным-выраженным гомогенным усилением в большинстве случаев. При помощи КТ диагностируются около 90 % менингиом. Главная роль КТ — демонстрация изменения костей и кальцинатов в опухоли.
ПЭТ
Ввиду высокой себестоимости метода и относительно низкой специфичности, в диагностике менингиом широкого распространения не получил.
Ангиография
Позволяет визуализировать кровоснабжение опухоли. С учётом инвазивности и лучевой нагрузки, значение в основном вспомогательное. Однако в сочетании с селективной эмболизацией сосудов опухоли может быть использован как метод предоперационной подготовки, а в ряде случаев и как самостоятельный метод лечения.
Лечение

Большинство менингиом имеют доброкачественный характер, и основным методом их лечения является хирургическое удаление.
Тяжесть хирургической операции и её исход, в основном, определяются расположением опухоли — её близостью к функционально значимым отделам мозга и соотношением с анатомическими структурами — сосудами и нервами.
В большинстве случаев радикальное удаление менингиомы обеспечивает фактически «излечение» или снижает риск повторного образования опухоли (рецидива) практически до нуля. Небольшая категория менингиом, имеющих недоброкачественный характер, склонна к быстрому рецидивированию, что требует повторных операций.
Помимо хирургического, другие методы в лечении менингиом используются относительно редко.
Обычная, ротационная гамма-терапия (лучевая терапия, облучение) малоэффективна в лечении большинства вариантов менингиом. Стереотаксические методики облучения применяются, в первую очередь, для лечения опухолей, расположенных в труднодоступных для хирургического удаления или в функционально значимых зонах. Стереотаксическая радиохирургия применима для лечения опухолей сравнительно небольшого размера (до 3,5 см в диаметре). Стереотаксическая радиотерапия применима также и для опухолей большего размера. Часто стереотаксическое облучение используется в сочетании с хирургическим лечением (в основном после операции для снижения риска рецидива, облучения части опухоли, которая не могла быть удалена при хирургической операции).
Химиотерапия в лечении доброкачественных менингиом не применяется.
Прогноз
Зависит от локализации, распространённости процесса и гистологического типа менингиомы. Доброкачественные менингиомы (без атипии, grade-1), будучи хирургически тотально удалены, не рецидивируют и не требуют дальнейшего лечения. Однако тотальное удаление даже доброкачественных менингиом в ряде случаев (менингиомы фалькс-тенториального угла, петрокливальные, кавернозного синуса, основания черепа, множественные) является затруднительным.
по локализации
Так, согласно исследованиям, конвекситальные менингиомы (свода черепа) после полного удаления имеют 3 % вероятность рецидивирования в течение последующих пяти лет. Для параселлярных этот показатель выше — 19 %, тела основной кости — 34 %.[19] Наиболее же высоким 5-летним индексом рецидивирования обладают менингиомы крыльев основной кости с вовлечением кавернозного синуса — 60–100 %[20].
по гистологии
Немаловажное значение в отношении прогноза имеет и гистологический тип. Доброкачественные (grade-1) менингиомы имеют 3 % индекс рецидивирования в течение 5 лет после полного удаления. Для атипичных и злокачественных (grade-2 и grade-3) он равен 38 % и 78 % соответственно[21].
Литература
- Гринберг М. С. Нейрохирургия. — Москва: МЕДпресс-информ, 2010. — 1008 с. — ISBN 978-5-98322-550-3.
- Joung H. Lee. Meningiomas. — Springer, 2008. — 639 p. — ISBN 978-1-84628-526-4.
Примечания
- ↑ Monarch Disease Ontology release 2018-06-29 — 2018-06-29 — 2018.
- ↑ Cushing H. The meningiomas (dural endotheliomas): their source and favored seats of origin (Cavendish Lecture). Brain. 1922;45:282–316.
- 1 2 3 4 5 Архангельский В. В., Бродская И. А. Менингиома // Большая медицинская энциклопедия / под общей редакцией Б. В. Петровского. — 3-е издание. — М.: «Советская энциклопедия», 1981. — Т. 15 (Меланома — Мудров). — С. 26—27. — 576 с. — 150 000 экз.
- 1 2 Батороев Ю. К. О новых нозологических формах ВОЗ-классификации опухолей центральной нервной системы (четвёртое переиздание, 2007) // Сибирский медицинский журнал. — 2009. — № 1. — С. 5—12. (недоступная ссылка)
- ↑ Zülch K. J. Histological typing of the tumors of the central nervous system. International classification of tumors. — World Health Organization. — Geneva, 1979.
- ↑ Kleihues P., Burger P. C., Scheithauer B. W. Histological typing of the tumors of the central nervous system. International classification of tumors. 2nd ed.. — World Health Organization. — Berlin, 1993.
- ↑ Dietzmann K., von Bossanyi P., Warich-Kirches M. et al. Immunohistochemical detection of vascular growth factors in angiomatous and atypical meningiomas, as well as hemangiopericytomas (англ.) // Pathol Res Pract. — 1997. — Vol. 193, no. 7. — P. 503—510. — doi:10.1016/S0344-0338(97)80104-5. — PMID 9342757.
- ↑ Ng H. K., Tse C. C., Lo S. T. Microcystic meningiomas--an unusual morphological variant of meningiomas (англ.) // Histopathology. — 1989. — Vol. 14, no. 1. — P. 1—9. — doi:10.1111/j.1365-2559.1989.tb02109.x. — PMID 2925174.
- ↑ Probst-Cousin S., Villagran-Lillo R., Lahl R. et al. Secretory meningioma: clinical, histologic, and immunohistochemical findings in 31 cases (англ.) // Cancer. — 1997. — Vol. 79, no. 10. — P. 2003—2015. — PMID 9149029. Архивировано 7 марта 2016 года.
- ↑ Harmouch T., Colombat M., El Amri A. et al. Lipomatous meningioma: two case reports // Ann Pathol. — 2005. — Vol. 25, № 2. — P. 389—392. — PMID 16498292.
- 1 2 Jääskeläinen J., Haltia M., Servo A. Atypical and anaplastic meningiomas: radiology, surgery, radiotherapy, and outcome // Surg Neurol. — 1986. — Vol. 25, № 3. — P. 233—242. — PMID 3945904.
- ↑ Bondy M, Ligon BL. Epidemiology and etiology of intracranial meningiomas: A review. J Neurooncol 1996;29:197–205.
- ↑ Longstreth WT Jr, Dennis LK, McGuire VM, et al. Epidemiology of intracranial meningioma. Cancer 1993;72:639–48.
- ↑ Kurland LT, Schoenberg BS, Annegers JF, et al. The incidence of primary intracranial neoplasms in Rochester, Minnesota, 1935–1977. Ann NY Acad Sci 1982;381:6–16.
- ↑ Alessandro GD, Giovanni MD, Iannizzi L, et al. Epidemiology of primary intracranial tumors in the Valle d’Aosta (Italy) during the 6-year period 1986–1991. Neuroepidemiology 1995;14: 139–46.
- ↑ Rohringer M, Sutherland GR, Louw DF, et al. Incidence and clinicopathological features of meningioma. J Neurosurg 1989;71:665–72.
- ↑ Christensen HC, Kosteljanetz M, Johansen C. Incidence of gliomas and meningiomas in Denmark, 1943 to 1997. Neurosurgery 2003;52:1327–34.
- ↑ Bret P, Lecuire J, Lapras C, et al. [Intraspinal meningiomas. A series of 60 cases]. Neurochirurgie 1976; 22:5–22.
- ↑ Mirimanoff RO, Dosoretz DE, Linggood RM, et al. Meningioma: analysis of recurrence and progression following neurosurgical resection. J Neurosurg 1985;62:18–24.
- ↑ Mathiesen T, Lindquist C, Kihlström L, et al. Recurrence of cranial base meningiomas. Neurosurgery 1996;39:2–9.
- ↑ Palma L, Celli P, Franco C, et al. Long-term prognosis for atypical and malignant meningiomas: a study of 71 surgical cases. J Neurosurg 1997;86:793–800.
Ссылки
- Клиническая презентация больной с субтенториальной менингиомой (iNeurologist)
- Клиническая презентация больной с рецидивом атипичной менингиомы (iNeurologist)